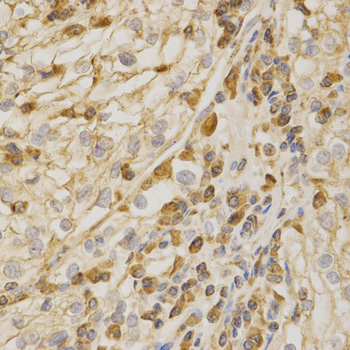

Anti-BAK1 Antibody
A35429
ApplicationsImmunoFluorescence, Western Blot, ImmunoHistoChemistry
Product group Antibodies
ReactivityHuman, Mouse, Rat
Overview
- SupplierAntibodies.com
- Product NameAnti-BAK1 Antibody
- Delivery Days Customer7
- ApplicationsImmunoFluorescence, Western Blot, ImmunoHistoChemistry
- CertificationResearch Use Only
- ClonalityPolyclonal
- Concentration1.0 mg/ml
- ConjugateUnconjugated
- HostRabbit
- Scientific DescriptionRabbit polyclonal antibody to BAK1
- ReactivityHuman, Mouse, Rat
- UNSPSC12352203

![BAK antibody [N1N2], N-term detects BAK protein at mitochondria by immunohistochemical analysis. Sample: Paraffin-embedded human colon. BAK stained by BAK antibody [N1N2], N-term (GTX100063) diluted at 1:500. Antigen Retrieval: Citrate buffer, pH 6.0, 15 min](https://www.genetex.com/upload/website/prouct_img/normal/GTX100063/GTX100063_44328_20220318_IHC-P_w_23053123_465.webp)